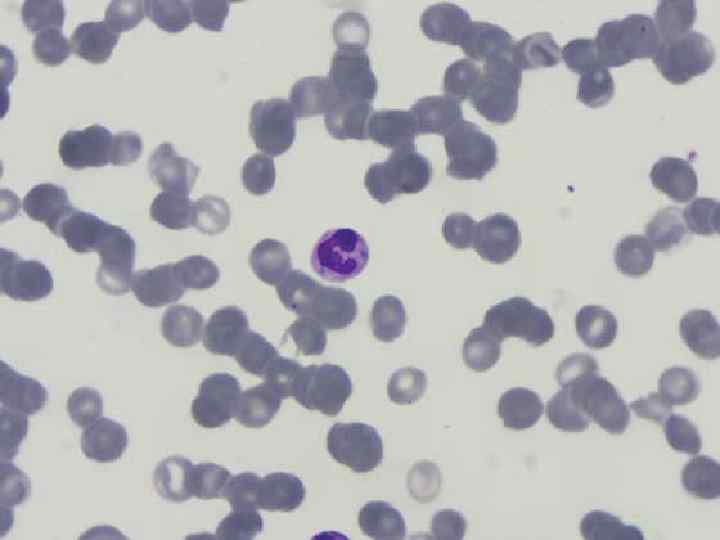

MDS.pptx
- Количество слайдов: 35
 MYELODİSPLASTİK SENDROM
MYELODİSPLASTİK SENDROM
 MDS yetersiz eritropoez ve sitopenilerin varlığı ile ortaya çıkan heterojen klonal bir kök hücre hastalığıdır. ABD’de tüm yaş gruplarında 100. 000 de 3 -5 iken 70 yaş üzerinde bu oran 22 -45 e çıkmakta ve yaşla artmaktadır. Ülkemizde sıklığı belirleyecek geniş bir epidemiyolojik veri bulunmamaktadır.
MDS yetersiz eritropoez ve sitopenilerin varlığı ile ortaya çıkan heterojen klonal bir kök hücre hastalığıdır. ABD’de tüm yaş gruplarında 100. 000 de 3 -5 iken 70 yaş üzerinde bu oran 22 -45 e çıkmakta ve yaşla artmaktadır. Ülkemizde sıklığı belirleyecek geniş bir epidemiyolojik veri bulunmamaktadır.
 Etyoloji Benzen, pestisidler, radyasyon, radyoterapi, kemoterapötik ilaçlar, sitogenetik anormallikler; en sık görüleni 5 q delesyonudur.
Etyoloji Benzen, pestisidler, radyasyon, radyoterapi, kemoterapötik ilaçlar, sitogenetik anormallikler; en sık görüleni 5 q delesyonudur.
 Klinik Anemi/bisitopeni/trombositopeni olabilir. Anemi genelde makrositerdir. (nonmegaloblastik) Genelde anemi semptomları ile gelirler. Geç dönemde kemik iliği yetmezliğine bağlı enfeksiyon ve kanamalar olguların %40’ında görülür. Olguların %30’u AML ye dönüşür (en sık AML-M 5)
Klinik Anemi/bisitopeni/trombositopeni olabilir. Anemi genelde makrositerdir. (nonmegaloblastik) Genelde anemi semptomları ile gelirler. Geç dönemde kemik iliği yetmezliğine bağlı enfeksiyon ve kanamalar olguların %40’ında görülür. Olguların %30’u AML ye dönüşür (en sık AML-M 5)
 Periferik yayma Makrositoz ağırlıkta Trombositler büyük ve granülsüzdür Pelger huet anomalisi(dumble şeklinde çekirdekli nötrofiller) Ring formasyonu veya anormal segmentli hipogranüle lökositler(Döhle cisimciği) Total lökosit sayısı normal ya da düşüktür
Periferik yayma Makrositoz ağırlıkta Trombositler büyük ve granülsüzdür Pelger huet anomalisi(dumble şeklinde çekirdekli nötrofiller) Ring formasyonu veya anormal segmentli hipogranüle lökositler(Döhle cisimciği) Total lökosit sayısı normal ya da düşüktür

Kemik İliği Genelde normoselüler ya da hiperselülerdir Displastik değişiklikler görülür Halkalı sideroblastlar görülebilir Blast sayısı artmıştır
Kemik İliği Genelde normoselüler ya da hiperselülerdir Displastik değişiklikler görülür Halkalı sideroblastlar görülebilir Blast sayısı artmıştır

 Dünya sağlık örgütü(2008) MDS sınıflaması ALT TİP • Tek dizide displazi ile seyreden refrakter sitopeniler(RCUD) • Refrakter anemi(RA) • Refrakter nötropeni(RN) • Refrakter trombositopeni(RT) ÇEVRE KANI • Tek veya iki dizide sitopeni • Blast nadir veya yok KEMİK İLİĞİ • Tek dizide displazi: etkilenen dizide ≥ %10 displazi • Blast < %5 • Halka sideroblast < % 15
Dünya sağlık örgütü(2008) MDS sınıflaması ALT TİP • Tek dizide displazi ile seyreden refrakter sitopeniler(RCUD) • Refrakter anemi(RA) • Refrakter nötropeni(RN) • Refrakter trombositopeni(RT) ÇEVRE KANI • Tek veya iki dizide sitopeni • Blast nadir veya yok KEMİK İLİĞİ • Tek dizide displazi: etkilenen dizide ≥ %10 displazi • Blast < %5 • Halka sideroblast < % 15
 Alt tip Çevre kanı Kemik iliği • Halka sideroblastlı refrakter anemi (RARS) • Anemi var Blast yok • Sadece eritroid displazi Halka sideroblast ≥ %15 • Çoklu dizide displazili refrakter sitopeni (RCMD) • Sitopeni(ler) Blast <% 1 Auer cisimciği yok Monosit<1000/mm³ • ≥ 2 myeloid dizide ≥ %10 displazi Blast < % 5 Auer cisimciği yok +/- %15 Halka sideroblast
Alt tip Çevre kanı Kemik iliği • Halka sideroblastlı refrakter anemi (RARS) • Anemi var Blast yok • Sadece eritroid displazi Halka sideroblast ≥ %15 • Çoklu dizide displazili refrakter sitopeni (RCMD) • Sitopeni(ler) Blast <% 1 Auer cisimciği yok Monosit<1000/mm³ • ≥ 2 myeloid dizide ≥ %10 displazi Blast < % 5 Auer cisimciği yok +/- %15 Halka sideroblast
 Alt tip Çevre kanı Kemik iliği • Artmış blastlı refrakter anemi-I (RAEB-I) • Sitopeni(ler) Blast< %5 Auer cisimciği yok Monosit<1000/mm³ • Tek veya çok dizide dizplazi %59 Blast Auer cisimciği yok • Artmış blastlı refrakter anemi II (RAEB-II) • Sitopeni(ler) Bast< %5 -9, Auer cisimciği +/Monosit<1000/mm³ • Tek veya çok dizide dizplazi %5 -19 Blast Auer cisimciği +/-
Alt tip Çevre kanı Kemik iliği • Artmış blastlı refrakter anemi-I (RAEB-I) • Sitopeni(ler) Blast< %5 Auer cisimciği yok Monosit<1000/mm³ • Tek veya çok dizide dizplazi %59 Blast Auer cisimciği yok • Artmış blastlı refrakter anemi II (RAEB-II) • Sitopeni(ler) Bast< %5 -9, Auer cisimciği +/Monosit<1000/mm³ • Tek veya çok dizide dizplazi %5 -19 Blast Auer cisimciği +/-
 Kemik iliği Çevre kanı Alt tip • Sınıflanmamış MDS (MDS-U) • Sitopeniler Blast ≤ % 1 • İzole del 5 q • Anemi, Normal/artmış trombosit sayısı Blast <%1 • Bir veya daha fazla myeloid hücre dizisinde < %10 displazi Blast <% 5 • Çekirdeği az lobüllü normal veya artmış megakaryosit Blast < %5, Sitogenetik olarak izole del 5 q Auer cisimciği yok
Kemik iliği Çevre kanı Alt tip • Sınıflanmamış MDS (MDS-U) • Sitopeniler Blast ≤ % 1 • İzole del 5 q • Anemi, Normal/artmış trombosit sayısı Blast <%1 • Bir veya daha fazla myeloid hücre dizisinde < %10 displazi Blast <% 5 • Çekirdeği az lobüllü normal veya artmış megakaryosit Blast < %5, Sitogenetik olarak izole del 5 q Auer cisimciği yok


 Riske göre MDS sınıflaması Düşük risk grubu IPSS’e göre düşük risk ve orta-1 risk Yüksek risk grubu Orta-2 risk, yüksek risk Orta-1 risk+kompleks sitogenetik bozukluk, tedaviye ikincil MDS, ağır sitopenisi olan ve standart tedaviye yanıt vermeyen olgular
Riske göre MDS sınıflaması Düşük risk grubu IPSS’e göre düşük risk ve orta-1 risk Yüksek risk grubu Orta-2 risk, yüksek risk Orta-1 risk+kompleks sitogenetik bozukluk, tedaviye ikincil MDS, ağır sitopenisi olan ve standart tedaviye yanıt vermeyen olgular
 Düşük Riskli MDS de Tedavi Eritropez Uyarıcı İlaçlar İle Tedavi EUİ kararı verilmesinde ; s-EPO düzeyi ve aylık transfüzyon gereksinimi ölçüt olarak kullanılmaktadır. Hemoglaobin düzeyi 10 gr/dl üzerinde ise sıklıkla tedaviye gerek yoktur. Genel olarak RARS haricinde tedaviye 8 hafta boyunca EPO/DA ‘dan birisi ile başlanması önerilir. Eğer yanıt yoksa 8 hafta G-CSF ilavesi ile devam edilir.
Düşük Riskli MDS de Tedavi Eritropez Uyarıcı İlaçlar İle Tedavi EUİ kararı verilmesinde ; s-EPO düzeyi ve aylık transfüzyon gereksinimi ölçüt olarak kullanılmaktadır. Hemoglaobin düzeyi 10 gr/dl üzerinde ise sıklıkla tedaviye gerek yoktur. Genel olarak RARS haricinde tedaviye 8 hafta boyunca EPO/DA ‘dan birisi ile başlanması önerilir. Eğer yanıt yoksa 8 hafta G-CSF ilavesi ile devam edilir.
 Düzenli transfüzyon gereksinimi olan RARS ‘li olgularda EPO/DA + G-CSF birlikte başlanmalı ve 16 hafta uygulanmalı yanıt değerlendirmesi 16. haftada yapılmalıdır , yanıt yoksa tedavi sonlandırılmalıdır. Tedavide hedef hemoglobin 12 gr/dl ‘dir.
Düzenli transfüzyon gereksinimi olan RARS ‘li olgularda EPO/DA + G-CSF birlikte başlanmalı ve 16 hafta uygulanmalı yanıt değerlendirmesi 16. haftada yapılmalıdır , yanıt yoksa tedavi sonlandırılmalıdır. Tedavide hedef hemoglobin 12 gr/dl ‘dir.
 EPO Tedavisi Tedavide EPO 60. 000 U/hafta ile başlanır. 8. haftada yanıt değerlendirilir yetersiz ise 900 U /kg ‘a kadar çıkılabilir Yetersiz yanıtta ikinci 8 haftalık dilimde G-CSF eklenerek devam edilir Eğer tam eritroid yanıt oluştu ise (Hb>12 gr/dl) 8 haftada bir olmak üzere EPO dozu düşürülerek devam edilmesi gerekir(60 -40 -30 -… 5000)
EPO Tedavisi Tedavide EPO 60. 000 U/hafta ile başlanır. 8. haftada yanıt değerlendirilir yetersiz ise 900 U /kg ‘a kadar çıkılabilir Yetersiz yanıtta ikinci 8 haftalık dilimde G-CSF eklenerek devam edilir Eğer tam eritroid yanıt oluştu ise (Hb>12 gr/dl) 8 haftada bir olmak üzere EPO dozu düşürülerek devam edilmesi gerekir(60 -40 -30 -… 5000)
 Darbopoetin(DA) tedavisi Tedaviye başlama dozu 150 µg/hafta veya 300 µg/14 gündür G-CSF Tedavisi Haftalık 300µg dozda 1 -3 doza bülünerek veya 1 -2µg/kg haftada 1 -3 sc uygulanır. Nötrofil sayısı 6. 000 -10. 000/mm³ arasında olduğunda G-CSF kesilir. 16. haftadan sonra yanıtın alınmadığı durumlarda hipometile edici ajanlara geçilmesi önerilir.
Darbopoetin(DA) tedavisi Tedaviye başlama dozu 150 µg/hafta veya 300 µg/14 gündür G-CSF Tedavisi Haftalık 300µg dozda 1 -3 doza bülünerek veya 1 -2µg/kg haftada 1 -3 sc uygulanır. Nötrofil sayısı 6. 000 -10. 000/mm³ arasında olduğunda G-CSF kesilir. 16. haftadan sonra yanıtın alınmadığı durumlarda hipometile edici ajanlara geçilmesi önerilir.
 İmmün süpresif tedavi Semptomatik ve transfüzyon bağımlı anemi, trombositopeni veya infeksiyon duyarlılığında artışa yol açan nötrepeninin eşlik ettiği refrakter anemili(RA) ve çoklu dizide displazili refrakter sitopenili (RCMD) hastalarda aşağıdaki durumlarda tercih edilir;
İmmün süpresif tedavi Semptomatik ve transfüzyon bağımlı anemi, trombositopeni veya infeksiyon duyarlılığında artışa yol açan nötrepeninin eşlik ettiği refrakter anemili(RA) ve çoklu dizide displazili refrakter sitopenili (RCMD) hastalarda aşağıdaki durumlarda tercih edilir;
 < 70 yaş IPSS düşük veya orta-1 HLA-DR 15 pozitifiğinde Kemik iliği hiposellülaritesi olan Normal sitogenetik Paroksismal nokturnal hemoglobinürü klonu olan hastalarda Antitimosit globulin(ATG) ve Siklosporin. A kulanılır
< 70 yaş IPSS düşük veya orta-1 HLA-DR 15 pozitifiğinde Kemik iliği hiposellülaritesi olan Normal sitogenetik Paroksismal nokturnal hemoglobinürü klonu olan hastalarda Antitimosit globulin(ATG) ve Siklosporin. A kulanılır
 İmmunmodulatör ilaçlar Lenalidomide Kullanım alanları: Düşük/orta-1 risk grubunda, semptomatik sitopeni(tek veya çoklu dizi) olan hastalarda; s EPO> 500 U/L olan, immunsupresif tedaviye uygun olmayan veya yanıtsız olan anemik olgularda İzole veya diğer anormalliklerle birlikte 5 q delesyonu olan hastalarda 10 mg/gün 21 gün süreyle 28 günde bir
İmmunmodulatör ilaçlar Lenalidomide Kullanım alanları: Düşük/orta-1 risk grubunda, semptomatik sitopeni(tek veya çoklu dizi) olan hastalarda; s EPO> 500 U/L olan, immunsupresif tedaviye uygun olmayan veya yanıtsız olan anemik olgularda İzole veya diğer anormalliklerle birlikte 5 q delesyonu olan hastalarda 10 mg/gün 21 gün süreyle 28 günde bir
 Talidomid Genel olara MDS’de endikasyonu olmamakla birilikte refrakter anemi alt grubunda ülkemiz dışında yanıt gözlenmiş. Yaşlılık ve doğurganlık çağındaki kadınlarda genellikle önerilmemekte
Talidomid Genel olara MDS’de endikasyonu olmamakla birilikte refrakter anemi alt grubunda ülkemiz dışında yanıt gözlenmiş. Yaşlılık ve doğurganlık çağındaki kadınlarda genellikle önerilmemekte
 Hipometilasyon yapıcı ajanlar Kullanım alanlar: Düşük/orta-1 risk grubunda, sitopenisi veya semptomatik anemisi olan hastalarda -s. EPO> 500 U/L olan, diğer tedavi seçeneklerine uygun olmayan veya yanıtsız olan anemik hastalarda -Ağır trombositopeni ve nötropenisi olan olgularda -s. EPO<500 U/L ve EUİ’ a yanıtsız olan olgularda
Hipometilasyon yapıcı ajanlar Kullanım alanlar: Düşük/orta-1 risk grubunda, sitopenisi veya semptomatik anemisi olan hastalarda -s. EPO> 500 U/L olan, diğer tedavi seçeneklerine uygun olmayan veya yanıtsız olan anemik hastalarda -Ağır trombositopeni ve nötropenisi olan olgularda -s. EPO<500 U/L ve EUİ’ a yanıtsız olan olgularda
 Azasitidin 75 mg/m² SC 1 -7 gün 28 günde bir RAEB-1 ve RAEB-2: kemik iliğinde blast oranının %5’in üzerinde olduğu MDS Kök hücre adayı olmayan ve kemik iliğinde blast artışı %5’in üzerinde olan KMML ve her üç seride displazi ve %2030 üzerinde blast artışı olan AML tedavisinde en fazla 4 kür kullanılabilir.
Azasitidin 75 mg/m² SC 1 -7 gün 28 günde bir RAEB-1 ve RAEB-2: kemik iliğinde blast oranının %5’in üzerinde olduğu MDS Kök hücre adayı olmayan ve kemik iliğinde blast artışı %5’in üzerinde olan KMML ve her üç seride displazi ve %2030 üzerinde blast artışı olan AML tedavisinde en fazla 4 kür kullanılabilir.
 Desitabin Kullanım alanları azasitidin ile aynı KMML ve AML ‘de endikasyon yoktur. 4 haftada bir 20 mg/m²/gün 5 gün IV 4 kür sonra yanıt değerlendirilir.
Desitabin Kullanım alanları azasitidin ile aynı KMML ve AML ‘de endikasyon yoktur. 4 haftada bir 20 mg/m²/gün 5 gün IV 4 kür sonra yanıt değerlendirilir.
 Yüksek riskli MDS’de tedavi A-Yüksek yoğunlukta tedavi için uygun olan hastalar Verici varsa allogenik kök hücre nakli yapılmalı Verici yoksa veya hasta nakle uygun değilse hipometilasyon yapıcı ilaç içeren rejimler , AML benzeri tedaviler uygulanabilir B-Yüksek yoğunlukta tedavi için uygun olmayan hastalar Hipometilasyon yapıcı ilaç içeren rejimler Düşük doz kemoterapi Destek tedavisi ve deneysel tedavi uygulanabilir.
Yüksek riskli MDS’de tedavi A-Yüksek yoğunlukta tedavi için uygun olan hastalar Verici varsa allogenik kök hücre nakli yapılmalı Verici yoksa veya hasta nakle uygun değilse hipometilasyon yapıcı ilaç içeren rejimler , AML benzeri tedaviler uygulanabilir B-Yüksek yoğunlukta tedavi için uygun olmayan hastalar Hipometilasyon yapıcı ilaç içeren rejimler Düşük doz kemoterapi Destek tedavisi ve deneysel tedavi uygulanabilir.
 Allogenik hemotopoetik kök hücre nakli IPSS göre orta-2 veya yüksek risk, Dirençli sitopeni, ileri yaş esas alınarak yüksek riskli olan hastalarda mümkün olduğunca hızlı yapılmalıdır. Yüksek yoğunlukta tedavi için uygun olmayan hastalarda düşük doz kemoterapi Melfalan Semptomatik, normal karyotip, hipo/normoselüler iliği olan yüksek riskli MDS, MDS/AML hastaları 2 mg/gün yanıta(genellikle 8 hafta)veya ilerlemeye kadar. Sitozin arabinozid 10 -30 mg/m²/gün SC 2 -8 hafta
Allogenik hemotopoetik kök hücre nakli IPSS göre orta-2 veya yüksek risk, Dirençli sitopeni, ileri yaş esas alınarak yüksek riskli olan hastalarda mümkün olduğunca hızlı yapılmalıdır. Yüksek yoğunlukta tedavi için uygun olmayan hastalarda düşük doz kemoterapi Melfalan Semptomatik, normal karyotip, hipo/normoselüler iliği olan yüksek riskli MDS, MDS/AML hastaları 2 mg/gün yanıta(genellikle 8 hafta)veya ilerlemeye kadar. Sitozin arabinozid 10 -30 mg/m²/gün SC 2 -8 hafta
 Destek tedavileri 1 -Transfüzyon Eritrosit süspansiyonu (semptomatik anemi) Trombosit süspansiyonu(trombositopenik orta ve ağır kanamalar için) lökositleri azaltılmış ve ışınlanmış ürünler tercih edilmeli 2 -Demir şelasyonu DSÖ sınıflamasına göre RA, RARS ve 5 q del olan hastalarda yaş çok ileri değilse ve eşlik eden ağır hastalık yoksa En az 1 yıl yaşam beklentisi olan transfüzyon bağımlı MDS hastalarında
Destek tedavileri 1 -Transfüzyon Eritrosit süspansiyonu (semptomatik anemi) Trombosit süspansiyonu(trombositopenik orta ve ağır kanamalar için) lökositleri azaltılmış ve ışınlanmış ürünler tercih edilmeli 2 -Demir şelasyonu DSÖ sınıflamasına göre RA, RARS ve 5 q del olan hastalarda yaş çok ileri değilse ve eşlik eden ağır hastalık yoksa En az 1 yıl yaşam beklentisi olan transfüzyon bağımlı MDS hastalarında
 Serum ferritin >1000 mcg/L veya toplam 20 Ü eritrosit transfüzyonu sonrası Kök hücre nakli adaylarının demir yüklenmesini önlemek gerekliliğinde -Deferroksamin -Deferasiroks -Deferipron
Serum ferritin >1000 mcg/L veya toplam 20 Ü eritrosit transfüzyonu sonrası Kök hücre nakli adaylarının demir yüklenmesini önlemek gerekliliğinde -Deferroksamin -Deferasiroks -Deferipron
 3 -Transeksamik asit kullanımı Düşük trombosit sayısı ve kanama eğilimi olanlarda 3 -4× 1 gr/gün kullanılmalı 4 -Enfeksiyonlardan korunma
3 -Transeksamik asit kullanımı Düşük trombosit sayısı ve kanama eğilimi olanlarda 3 -4× 1 gr/gün kullanılmalı 4 -Enfeksiyonlardan korunma
 Günümüzde MDS’de şifa sağlayıcı tek tedavi yöntemi 60 yaş altı ve uygun vericisi olan olgularda allogeneik hematopoetik kök hücre naklidir. Şifa oranı %30 -50 arasındadır.
Günümüzde MDS’de şifa sağlayıcı tek tedavi yöntemi 60 yaş altı ve uygun vericisi olan olgularda allogeneik hematopoetik kök hücre naklidir. Şifa oranı %30 -50 arasındadır.



